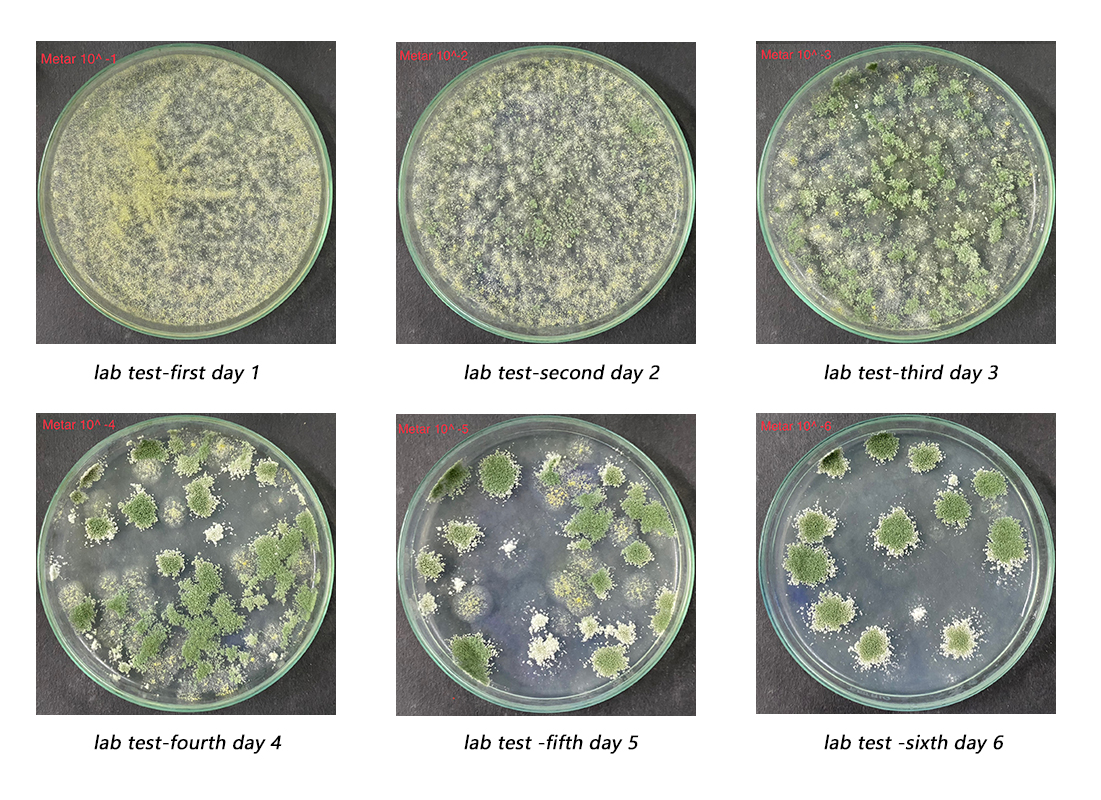
1729579980513885.jpg 未标题-1.jpg

绿僵菌/Metarhizium anisopliae
绿僵菌/Metarhizium anisopliae
杀虫原理Insecticidal principle
金龟子绿僵菌是一种昆虫寄生真菌,蝼蛄、蛴螬、金针虫、地老虎等地下害虫接触到这种真菌后,能粘附在害虫体表,并在产生芽管通过气孔进入害虫体内,吸取体内的营养物质,并在害虫体内进行大量繁殖,产生大量孢子,并产生毒素,将害虫体内的营养物质吸收干净,最终杀死害虫,还不断在害虫种群中不断传播,持续杀灭更多的害虫。该药剂对人畜无害,同时还具有不污染环境、害虫不会产生抗药性等优点。
Metarhizium anisopliae is an insect parasitic fungus. Underground pests such as mole crickets, grubs, beetles, and ground tigers can adhere to the surface of the pest after coming into contact with this fungus, and produce buds that enter the pest's body through stomata to absorb nutrients. They then reproduce extensively in the pest's body, producing a large number of spores and toxins, which absorb the nutrients from the pest's body and ultimately kill the pest. They continue to spread in the pest population, continuously killing more pests. This drug is harmless to humans and animals, and also has the advantages of not polluting the environment and preventing pests from developing resistance.
2、主要剂型 Main type
(1)100亿孢子/克 乳粉剂
Emulsifier powder 1X1010 conidia/g
将本品按一定比例兑水后灌根,或将本品按一定比例兑水稀释后,使用喷雾器进行常量喷雾,也可滴灌使用。
施药适期:害虫低龄幼虫期使用最为适宜遇大风和降雨天气,请勿施药,以免影响药液沉降和有效附着。
Suitable period for pesticide application: It is most suitable for use during the young larval stage of pests in strong winds and rainy weather. Do not apply pesticides to avoid affecting the settling and effective attachment of the pesticide solution.
(2) 100亿孢子/毫升 油悬浮剂
Oil suspension formulation 1X1010 conidia/mL
直接喷洒或用清水将油悬浮液稀释成1∶100至300份
Spray directly or dilute oil suspension with clearing water in 1: 100 to 300 rations.

实验培育图片(1-6天)